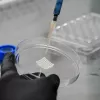
Científicos argentinos desarrollaron una biotinta de cannabis para regenerar tejidos con impresión 3D

El Departamento de Energía de Estados Unidos ha invertido 3,47 millones de dólares para el desarrollo de tecnologías que permitan la impresión 3D de materiales elaborados a partir del cáñamo industrial con los que construir casas asequibles. El proyecto será desarrollado por investigadores de la Universidad de Texas, quienes trabajaran en la forma de desarrollar maquinaria capaz de imprimir piezas arquitectónicas a base de polvo de cáñamo, fibras, cal y agua.
La subvención forma parte de un programa federal para el desarrollo de estructuras que sean capaces de absorber elementos contaminantes de la atmósfera. Esta es una de las varias ventajas que ofrece el cáñamo, entre cuyas propiedades se encuentra la capacidad de absorber elementos contaminantes del aire, así como elementos radioactivos del suelo mediante su cultivo.
“Si bien la producción de materiales de construcción convencionales, como el hormigón, requiere grandes cantidades de energía y libera grandes cantidades de CO2 (dióxido de carbono), el cáñamo es un material con emisiones netas de carbono negativas, lo que puede proporcionar importantes beneficios ambientales”, dijo a Marijuana Moment Petros Sideris, profesor asistente de la la universidad que actuará como investigador principal del proyecto.
Two faculty members, Manish Dixit and Wei Yan are on a project team which recently received $3.74 million in funding from the U.S. Department of Energy to research the development of 3-D printed buildings made of hempcrete. https://t.co/pdt0SxKd6s @TAMUEngineering @TAMU
— TAMU Architecture (@TAMUARCH) June 27, 2022